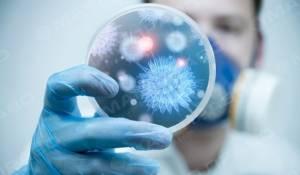
Свежие новости: В Николаеве грибы убивают людей

Происшествия | Николаев, 21 Октября, 2016
В Николаеве грибы убивают людей
На территории Николаевской области, за осенний период текущего года, есть уже случаи, отравления дикорастущими грибами. Новости Николаева
С 11 по 14 октября к спасателям дважды поступали сообщения о госпитализации горожан с предварительным диагнозом - отравление грибами, который был подтвержден клиническими исследованиями.
Главное управление ГСЧС Украины в Николаевской области обращается к жителям и гостям Николаева:
Будьте осторожны, соблюдайте всем известным правил безопасности при сборе, приготовлению и употреблению в пищу дикорастущих грибов. Берегите свое здоровье!
Источник: nikolaev-city.net
Читайте также
Завтра в Николаеве состоится прощание с Владиславом Волошиным
Завтра в Николаеве состоится прощание с Владиславом Волошиным ... Читать дальше













